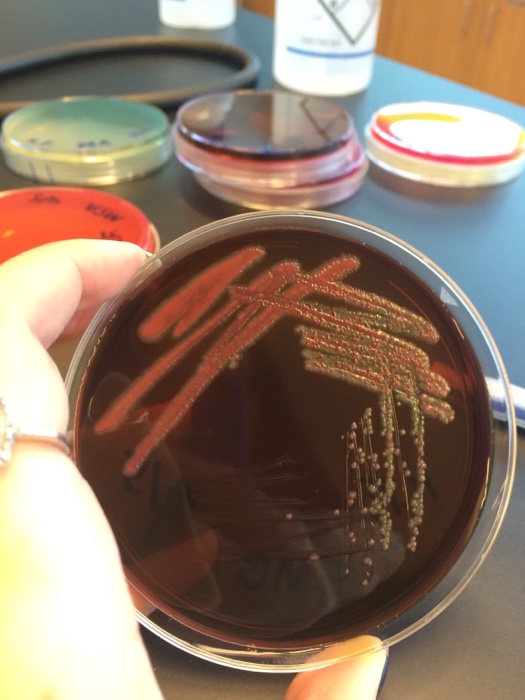

42 my math lab coupon
Ready to register? | Pearson MyLab & Mastering Please be patient. We need just a moment to get you to the right course. Bookstore @ Rio Salado Coupons & Promo Codes 2022 - Offers.com Bookstore @ Rio Salado Coupon Codes. Offers.com is supported by savers like you. When you buy through links on our site, we may earn an affiliate commission. Learn More. All Offers (5) Codes (1) Product Deals (1) In-Store (1) Discount Gift Cards (1) SALE Shop Rental & Digital Textbooks .
25% off MyLab Coupons & Promo Codes + Free Shipping 2022 100% Lab-Certified Home STD Tests . Verified. Get Offer . FREE SHIPPING Pcr Covid Tests as low as $99 + Free Shipping . Verified. Get Offer . FREE ... Popular MyLab Coupons. Discount Description Expires; 25% Off 25% off any order --- 20% Off 20% off any order + Free Shipping --- $15 Off $15 off any order + Free Shipping ---
My math lab coupon
Pearson Education Coupons: 16 Coupon Codes for June 2022 - TheRawFeed We feature (16) Pearson Education coupons, promo codes and deals for June 2022. Never miss a Pearson Education sale or online discount, updated daily. TheRawFeed; Browse; Sitemap; Reveal All ... Details: my math lab Show Coupon Code 6% success rate. Save 9.3% Coupon Code. 3% off. Details: 9.3% off. ... My Math Lab Code Sale : Save up to 21% - buycheapr.com 10% OFF MyMath Lab Access Card for School (1-year Access), 1/e S & H: see site $43.26 Amazon MyMath Lab: Student Access Kit S & H: see site $34.99 Amazon MyMath Lab / My Stat Lab: Student Version S & H: see site $41.15 Amazon imagi Lab s Girls Coding Gift, imagiCharm, Learn How to Code on Your Phone then Bring Designs to Life S & H: see site $99.00 How Do I Get A Pearson Access Code For MyMath Without Paying $100? anthonycarbine. · 3 yr. ago Pearson Student. This. IIRC I found a Pearson MML access code for about $75 on abebooks. It didn't come with the textbook, but I just pirate it anyways. It was an actual card that they mail to you. Worked like a charm. 3. level 1.
My math lab coupon. Get Registered | Students | MyLab Math | Pearson An access code, credit card, or PayPal. If you already have an access code, you'll redeem it when you register. If you don't, you can use a credit card or PayPal to purchase access. OK! Register now. Pearson Store Coupons | July 2022 - CouponChief.com COUPON CODE 30% My Math Lab w/code. Now grab 30% My Math Lab. A GET PROMO CODE. More details . Details; GET OFFER ; Expired: Expired over one year ago. Submitted: By martvb. Expired over one year ago. 20% OFF 20% Off purchase. Now you can get flat 20% Off on Your Order only at Pearson.com. Save 10% on ApplicantLab through GMAT Club Save 10% on ApplicantLab through GMAT Club World-class admissions consulting doesn't cost a fortune anymore. ApplicantLab's series of interactive online exercises takes you step-by-step through the exact same process and advice, but for a small fraction of the price with ApplicantLab. . My Math Assistant Get started Let My Math Assistant help you with Saxon Math.. Use your valuable time with your students more effectively! Start Your Free Trial Now
50% OFF Pearson Promo Codes & Discount Codes for July 2022 10% Off Selected Items. Catch the ending promotion on all orders, select your favorite products from wide range of products at Pearson. Just enjoy the deal:10% off selected items. Don't pass up the savings! MORE+. Expires: Jul 16, 2022 Last used 9 days ago. Get Code 20. 35% OFF. My Pearson Store Coupons: 51 Coupon Codes for June 2022 Details: Access to my math lab Show Coupon Code 6% success rate. Save 15% Coupon Code. 15% off entire purchase. Details: 15% off entire purchase ... Details: 50% coupon for my chemistry lab Show Coupon Code 0% success rate. 20% Deal. 20% Off Invisible Forces and Powerful Beliefs: Gravity, Gods, and Minds ebook ... MyLab Math | Buy | 9780321199911 | Chegg.com COUPON: RENT MyLab Math 4th edition (9780321199911) and save up to 80% on 📚textbook rentals and 90% on 📙used textbooks. ... Note: Supplemental material (e.g. CDs, DVDs, access codes, or lab manuals) is only included with a new textbook purchase. * Savings are calculated off list price. ... Rent 📙MyLab Math 4th edition (978-0321199911 ... MyMathLab: Student Access Kit 4th Edition - amazon.com MML stimulates better student/teacher interaction in a lab setting. It tracks and grades homework for you. And it's a great tutorial for students when they get stuck." from Sheila Pisa, Riverside Community College (CA) "MML is one of the most reliable of all online Math programs." from Sheila Pisa, Riverside Community College (CA) "I ...
Pearson Education Promo Codes, Coupons 2022 - RetailMeNot.com Expired Coupons 10% OFF Code 10% Off Your Order Show Coupon Code See Details 30% OFF Code 30% Off CCNA Routing & Switching, Security, And Voice Titles From Cisco Press Added by dealsaver Show Coupon Code See Details 35% OFF Code 35% Off Books And EBooks Added by dealsaver Show Coupon Code See Details 30% OFF Code Lab | Piggy Wiki | Fandom Appearance Normal Phase. It takes place at the Military Camp’s underground 2 story laboratory. There are gray hallways on the ground floor with cubes and white hallways on the bottom floor with red chairs and shelves, a big white experimental room which contains scientific equipment, a room which contains three holes that lead to the floor underneath the main floor, a room with the cure, a ... 100% Off and $10 Udemy Coupons | Learn Viral 1 day ago · July 12, 2022 // Duration: 5 hrs 17 mins // Lectures: 37 // Online guide on how to learn GAMS like a Pro. Complete Practical Examples, take your GAMS skills to the next level now! 80% Off My Pearson Store Coupon Code, Promo Code & Discount Codes 2018 → My Pearson Store Promo Code, → My Pearson Store Coupon Code, ... Access To My Math Lab 10. # Environmental Law Textbooks as low as $107.60 <3 <3 <3. Buy # Textbooks # CollegeText # books Online | # ISBNLookup | # PearsonBooks. See more. 80% Off My Pearson Store Coupon Code, Promo Code & Discount Codes 2018.
My Math Lab Flashcards | Quizlet A cereal company places a coupon bearing a number from 1 to 9 in each box of cereal. If the numbers are distributed at random in the boxes, estimate the number of boxes you would have to purchase in order to obtain all nine numbers. Explain how the random-digit table could be be used to estimate the number of coupons.
MyLab Math | Pearson With MyLab and Mastering, you can connect with students meaningfully, even from a distance. Built for flexibility, these digital platforms let you create a course to best fit the unique needs of your curriculum and your students. Each course has a foundation of interactive course-specific content — by authors who are experts in their field ...
Official NordVPN Coupon Codes - July 2022 | NordVPN Security shouldn't cost an arm and a leg. And it doesn't — not with NordVPN coupon codes. Save money on your online safety and security with our special deal.
Mymathlab Access Code Free - Math Problem Solver Mymathlab access code is available for FREE via access code and discount coupon. Mymathlab free access code MyMathLab refers to an online based interactive educational system that was designed by the renowned Pearson Education to accompany the math textbooks that they publish. You can buy the Access Code from Amazon.com for cheap.
MathXL Standalone Access Card (6-month access) - Pearson ISBN-13: 9780321878359. Online purchase price. $79.99. Net price. Instructors, sign in here to see net price. $59.99 (what's this?) Availability. Available.
GRE Math Practice Tests - Varsity Tutors Our completely free GRE Math practice tests are the perfect way to brush up your skills. Take one of our many GRE Math practice tests for a run-through of commonly asked questions. You will receive incredibly detailed scoring results at the end of your GRE Math practice test to help you identify your strengths and weaknesses.
Miller, Heeren, Hornsby & Heeren, Mathematical Ideas, 14th ... - Pearson John Hornsby joined the author team of Margaret Lial, Charles Miller, and Vern Heeren in 1988. In 1990, the 6th Edition of Mathematical Ideas became the first of nearly 150 titles he has coauthored for Scott Foresman, HarperCollins, Addison-Wesley, and Pearson in the years that have followed.
My Pearson Store Coupon May 2022 :get 60% Off - Dealscove Access to My Math Lab Show Code soon 59 0 0 COUPON CODE 30% My Math Lab Show Code soon 157 0 0 SALE DEAL Find Great Deals on Textbooks Show Deal soon 196 0 0 FREE SHIPPING DEAL Free standard shipping on your purchase Get Free Standard Shipping on ... more Show Deal soon 58 0 0 50% OFF DEAL Get 50% off on all your order
MyMathLab Plus Student Access Kit (standalone) 1st Edition by Pearson (Author) 3.8 out of 5 stars. 67 ratings. ISBN-13: 978-0321578075. ISBN-10: 0321578074. Why is ISBN important? ISBN. This bar-code number lets you verify that you're getting exactly the right version or edition of a book. The 13-digit and 10-digit formats both work.
Math Lab Worksheets Light My Stadium Math Lab: Rubric - Have students grade themselves with this nice additional assessment piece. Light My Stadium Math Lab: Spec Sheet - Materials that students will work with. Now that's using your head!- A fun basic graphing lab, that examines if your head size is related to how high you can jump. One, Two, Three Isaac Newton ...
My Math Assistant Simple, flexible pricing. Starting at only $4.99/month, you'll receive a tremendous amount of value for only a few dollars a month. Pay annually and receive 12 months for the price of 10! Single Student Family Plan (2-5 students) Video Lessons $ 4.99 /mo Video Lessons Facts Practice Online and Email Reports Flexible Options Customer Support
Teacher Resources and Classroom Supplies | hand2mind Want to keep learning over the summer fun and engaging? Choose from over 1,000 FREE downloadable lessons! Math, Literacy, STEM, and more for grades K-5!
Pearson eCollege Coupons Jul 2022: Coupon & Promo Codes 10% Off Coupon Code at Pearson eCollege REG11 40% Off Code 40% Off Select Items for Members at Pearson eCollege With This Coupon Code ED40 15% Off Code 15% Off Pearson eCollege Promo Code 22S1-USA Up To 15% Off Code Up to 15% Off All Orders 22S1-GRIFFITH 20% Off Code Save 20% Off Pearson eCollege when you use Coupon Code PSA20
MyMathDone.com Promo Code, Coupon Codes, Discounts And Vouchers 2022! MyMathDone.com - Promo Code 2022. December 15, ... The company can also provide a full range of assignments, from case studies to essays and lab reports to term papers and articles. There's even a section dedicated to dissertation services. ... My Math Done is an average service at best. With high prices, inconsistent quality in the content ...
MyLab & Mastering | Pearson Personalize learning, one student at a time. Today, reaching every student can feel out of reach. With MyLab and Mastering, you can connect with students meaningfully, even from a distance.

Post a Comment for "42 my math lab coupon"